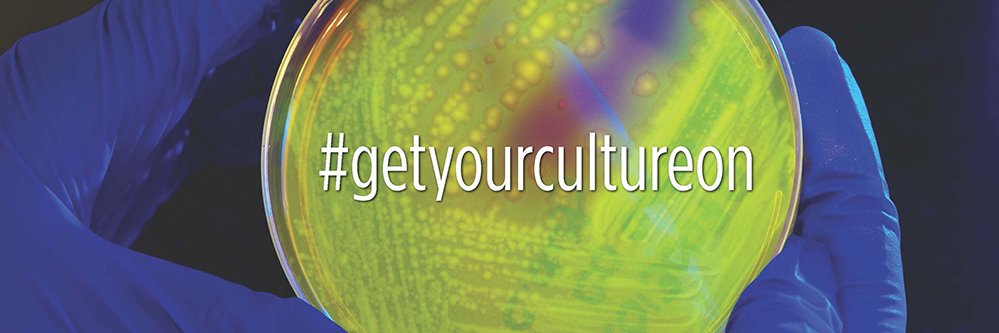
ABSA International banner

In June of 2026, we are so excited for the Principles & Practices of Biosafety in Charlotte, NC. This comprehensive course will introduce the essential elements of biosafety and provide extensive resource lists for use after the course.
Register here: absa-ppb.org

English